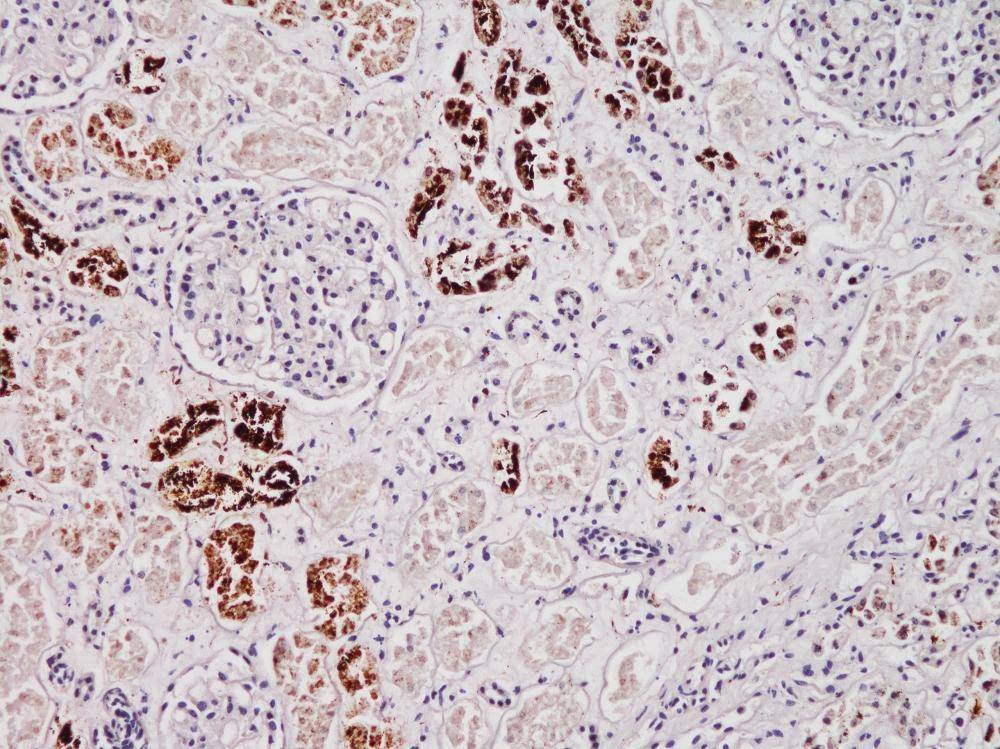

台灣海域銀濃度高 毒害鯨豚免疫能力
撰文 / 林雅容
 鯨豚擱淺帶來關於海洋的訊息,大海裡究竟發生了什麼事呢?
|
火車沿著東岸湛藍的海岸線奔馳,夏日豔陽下的大海,無風無浪,
我回頭再次望向平穩的大海,海面看似清澄如鏡,
台灣海域的銀濃度 世界第二高
「那隻弗氏海豚肝裡頭的銀含量高達700 ppm。」文達說,「國際上其他國家針對鯨豚體內銀濃度的調查,
講起話來條理分明、鏗鏘有力的文達,
 台灣擱淺鯨豚身上的銀濃度,高達世界第二。
|
自古以來,人們就發現銀具有廣泛殺菌的作用,
然而,水能載舟,亦能覆舟,奈米銀既然有強大的殺菌功能,
海中的銀降低鯨豚免疫力
「我們進行了兩個方向的實驗,一是實驗室裡的細胞供毒實驗,
細胞供毒實驗的步驟很簡單,
擱淺鯨豚體內銀濃度的檢測,
 鯨豚的白血球在特殊染色下,標示出進入細胞的銀。
(李文達提供) |
在鯨豚的腎臟組織可以偵測到銀。(李文達提供)
|
「肝和腎是處理毒物的器官,所以可見銀的累積。
大自然裡的重金屬,
屬於非毒性金屬的銀普遍被認為不具毒性,不會造成特定器官病變,
「因此,細胞供毒實驗和擱淺鯨豚的解剖結果是相符合的。
奈米銀的使用應該更為審慎
 鯨豚是哨兵動物,警告著我們環境上的變異。
|
目前,人類醫學的領域提出以奈米銀作為癌症的輔助治療之一,
奈米銀在環境上的汙染影響更為深遠。銀污染經由地表水排入大海,
「鯨豚累積從陸地沖刷到海裡的污染物,可說是生態中的哨兵動物,
上述成果,僅僅是奈米銀生態毒性的初步探討,接下來,





